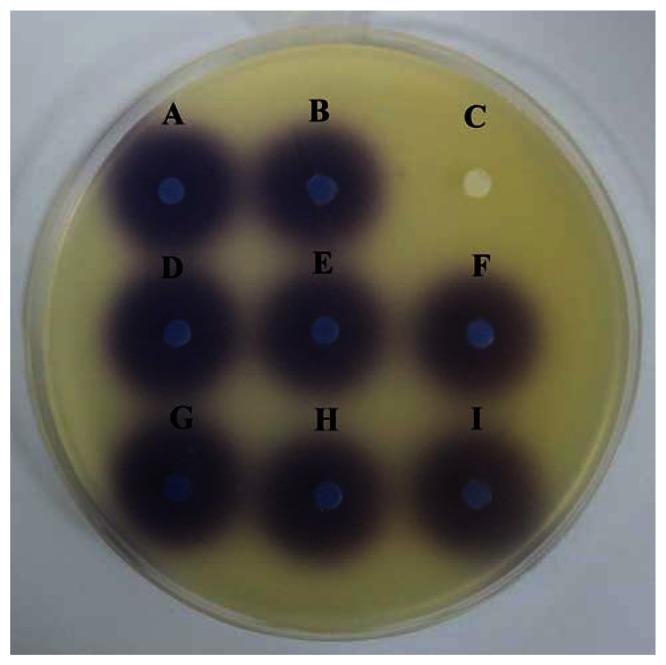
https://cdn.ncbi.nlm.nih.gov/pmc/blobs/3e5e/3673129/42df7cd1ec63/sensors-13-05117f4.jpg

咖啡因作为一种潜在的群体感应抑制剂。
Caffeine as a potential quorum sensing inhibitor.
机构信息
Division of Genetics and Molecular Biology, Institute of Biological Sciences, Faculty of Science, University of Malaya, Kuala Lumpur 50603, Malaysia.
出版信息
Sensors (Basel). 2013 Apr 18;13(4):5117-29. doi: 10.3390/s130405117.
Quorum sensing enables bacteria to control the gene expression in response to the cell density. It regulates a variety of bacterial physiological functions such as biofilm formation, bioluminescence, virulence factors and swarming which has been shown contribute to bacterial pathogenesis. The use of quorum sensing inhibitor would be of particular interest in treating bacterial pathogenicity and infections. In this work, we have tested caffeine as quorum sensing inhibitor by using Chromobacterium violaceum CV026 as a biosensor. We verified that caffeine did not degrade the N-acyl homoserine lactones tested. In this work, it is shown that caffeine could inhibit N-acyl homoserine lactone production and swarming of a human opportunistic pathogen, namely Pseudomonas aeruginosa PA01. To the best of our knowledge, this is the first documentation providing evidence on the presence of anti-quorum sensing activity in caffeine. Our work will allow caffeine to be explored as anti-infective drugs.
群体感应使细菌能够根据细胞密度来控制基因表达。它调节着各种细菌的生理功能,如生物膜形成、生物发光、毒力因子和群集运动,这些都被证明有助于细菌的发病机制。使用群体感应抑制剂在治疗细菌性发病和感染方面将具有特别的意义。在这项工作中,我们使用 Chromobacterium violaceum CV026 作为生物传感器来测试咖啡因作为群体感应抑制剂的效果。我们验证了咖啡因不会降解所测试的 N-酰基高丝氨酸内酯。在这项工作中,表明咖啡因可以抑制 N-酰基高丝氨酸内酯的产生和人类机会性病原体铜绿假单胞菌 PA01 的群集运动。据我们所知,这是首次有文献证明咖啡因具有抗群体感应活性。我们的工作将使咖啡因能够被探索作为抗感染药物。